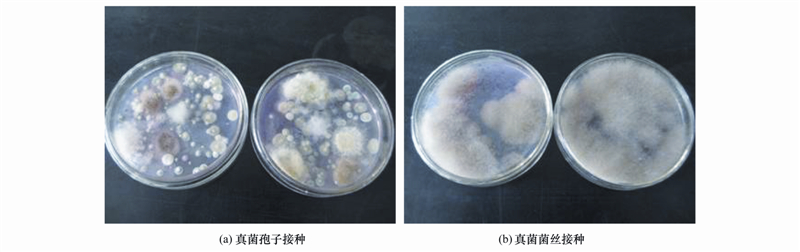

╬█─ÓųąĮzĀŅšµŠ·ī”╬█─Ó├ō╦«ąį─▄Ą─ė░Ēæ
ųąć°╬█╦«╠Ä└Ē╣ż│╠ŠW ĢrķgŻ║2016-12-10 9:46:23
╬█╦«╠Ä└Ē╝╝ąg | ģRŠ█╚½Ū“Łh▒Ż┴”┴┐Ż¼ĮĄĄ═Ų¾śIų╬╬█│╔▒Š
ĪĪĪĪĮžų┴2014─Ļ3į┬ĄūŻ¼╚½ć°įO╩ą│Ū╩ąĪó ┐h└█ėŗĮ©│╔│Ūµé╬█╦«╠Ä└ĒÅS3622ū∙Ż¼╚š╠Ä└Ē╬█╦«─▄┴”╝s1.53Ī┴109 m3[1]Ż¼╬█╦«╠Ä└ĒÅS├┐─Ļ«a╔·│¼▀^600╚ft╬█─Ó(ęįĖ╔ųžėŗ)[2,3]. Ą½╩Ū,─┐Ū░│Ūµé╬█╦«╠Ä└ĒÅS«a╔·Ą─ØŌ┐s╬█─Ó║¼╦«┬╩═©│ŻĖ▀▀_97%ū¾ėęŻ¼╚ń┤╦Ė▀Ą─╦«Ęų║¼┴┐ī¦ų┬╬█─Ó¾wĘe²ŗ┤¾Ż¼Įo╬█─ÓĄ─▐D▀\Īó ║¾└m╠Ä└Ē╠Äų├Č╝ĦüĒ┴╦║▄┤¾Ą─└¦ļy[4]. ę“┤╦,īżšę║Ž▀mĄ─ĘĮĘ©┤¾Ę∙ĮĄĄ═╬█─Ó╦«Ęų║¼┴┐Ż¼╩ŪĮŌøQ╬█─Ó│÷┬ĘĄ─ĻPµI╦∙į┌. «öŪ░Ż¼╠Ē╝ėĖ„ĘN╗»īWą§─²ä®▓ó▌oęįÖCąĄ├ō╦«ęįīŹ¼FĪ░─Ó╦«ĘųļxĪ▒Ą─ĘĮĘ©Ųš▒ķæ¬ė├ė┌╬ęć°╬█╦«╠Ä└ĒÅSŻ¼▀@ą®ą§─²ä®░³└©Š█▒¹Ž®§Ż░Ę(PAM)Īó ┬╚╗»ĶFĪó Š█║Ž┴“╦ßõX╗“Š█║Ž╚²┬╚╗»õX║═ų·─²ä®╚ń╩»╗ęĄ╚[5]. Ą½į┌┤╦ĘĮĘ©ųąŻ¼═Č╚ļĄ─┤¾┴┐¤oÖCą§─²ä®Ż¼Ģ■┤¾Ę∙į÷╝ėš¹éĆ╬█╦«╠Ä└Ē▀^│╠Ą─│╔▒ŠŻ¼ĮĄĄ═╬█─ÓųąėąÖC╬’║¼┴┐║═¤ßųĄŻ¼▓óį÷╝ėūŅĮKĄ─╬█─Ó┘|┴┐Ż¼Č°▓┐ĘųėąÖCą§─²ä®Ą─╠Ē╝ėätĢ■ĦüĒØōį┌Ą─Č■┤╬╬█╚Š’LļU[6].
ĪĪĪĪ╔·╬’Ę©ÅŖ╗»╬█─Ó├ō╦«╩ŪĮ³─ĻüĒ░lš╣ŲüĒĄ─ę╗ĘN╬█─Óš{└ĒĘĮĘ©Ż¼Ųõų„ę¬įŁ└Ē╩Ū═©▀^╬ó╔·╬’ūį╔Ē╗“╬ó╔·╬’Ą─┤·ųx«a╬’üĒĖ─╔Ų╬█─ÓĄ─├ō╦«ąį─▄[7]Ż¼┼c╠Ē╝ėĖ„ĘNą§─²ä®Ą─╗»īWĘ©ŽÓ▒╚Ż¼╔·╬’Ę©Š▀ėąą¦┬╩Ė▀Īó Č■┤╬╬█╚ŠąĪĄ╚╠ž³c[8]. ŲõųąŻ¼ė╔ė┌┴╝║├Ą─Ė─╔Ų╬█─Ó├ō╦«ąį─▄Ą─ą¦╣¹Ż¼æ¬ė├ĮzĀŅšµŠ·╠Ä└Ē╩ŻėÓ╬█─ÓĄ─ĘĮĘ©ęčĮøę²Ų┴╦ę╗ą®īWš▀Ą─ĻPūó[8, 9, 10, 11, 12, 13]. └²╚ńŻ¼MannanĄ╚[14]Ą─蹊┐▒Ē├„Ż¼ĮzĀŅšµŠ·Penicillium corylophilum(WWZP1003)║═Aspergillus niger (SCahmA103)Ęųäe╠Ä└Ē£ńŠ·Ą─╩ŻėÓ╬█─Ó(║¼╣╠┬╩×ķ0.5%~1%)2 d║¾Ż¼╬█─ÓĄ─▒╚ūĶÅ─╬┤╠Ä└ĒĢrĄ─1.36Ī┴1012 m Īżkg-1 ĮĄų┴0.093Ī┴1012 m Īżkg-1║═0.13Ī┴1012 m Īżkg-1Ż¼Ęųäe£p╔┘93.20%║═90.10%; Subramanian Ą╚[15,16]Å─╬█─ÓųąĘųļxĄĮ1ųĻĮzĀŅšµŠ·Penicillium expansum BS30Ż¼čąŠ┐░l¼Fė├┤╦Š·ųĻ╠Ä└Ē║¼╣╠┬╩×ķ1%Ą─╩ŻėÓ╬█─ÓŻ¼┐╔╩╣╬█─ÓĄ─├½╝Ü╬³╦«Ģrķg (CST) Å─80~245 sĮĄų┴12.6~16 sŻ¼╩╣╬█─ÓĄ─├ō╦«ąį─▄Ą├ĄĮ’@ų°Ė─╔Ų. Ą½─┐Ū░╦∙ĘųļxĄĮĄ─ĮzĀŅšµŠ·═©│Żų╗─▄╠Ä└Ē║¼╣╠┬╩Ą═ė┌1%Ą─╬█─ÓŻ¼═¼Ģr╠Ä└Ē╬█─ÓĢrąĶŽ╚īó╬█─Ó▀Mąą£ńŠ·ŅA╠Ä└Ē▓ó╠Ē╝ė═Ōį┤╠╝į┤Ż¼śO┤¾Ąž╠ßĖ▀┴╦╠Ä└Ē│╔▒Š[8, 9, 10, 11]. ę“┤╦Ż¼▒ŠčąŠ┐ćLįćÅ─╬█─ÓųąĘųļxĮzĀŅšµŠ·Ż¼▓óį┌╬█─Ó▓╗£ńŠ·║═▓╗╠Ē╝ė═Ōį┤╠╝į┤Ą─ŪķørŽ┬╠Ä└ĒĖ▀║¼╣╠┬╩╬█─ÓŻ¼Å─Č°ĻU├„┤╦ŅÉĮzĀŅšµŠ·Ė─╔Ų╬█─Ó├ō╦«ąį─▄Ą─╗∙▒ŠÖCųŲ╝░ė░Ēæę“╦žŻ¼ęįŲ┌×ķ╔·╬’Ę©ÅŖ╗»╬█─Ó├ō╦«╝╝ągĄ─░lš╣╠ß╣®ģó┐╝ę└ō■. 1 ▓─┴Ž┼cĘĮĘ© 1.1 ╣®įć╬█─Ó
ĪĪĪĪ╣®įć╬█─Ó╚ĪūįĮŁ╠K╩Ī¤oÕa╩ą╠½║■ą┬│Ū╬█╦«╠Ä└ĒÅSĄ─╬█─ÓØŌ┐s│ž. ▓╔╝»║¾┴ó╝┤£yČ©╬█─ÓpHĪó ║¼╣╠┬╩Īó ėąÖC┘|║¼┴┐Īó ╬█─Ó▒╚ūĶĪó ZetaļŖ╬╗║═╬█─Ó¾wĘeųĖöĄ. ╬█─Ó╗∙▒Š└Ē╗»ąį┘|╚ńŽ┬Ż║pH 7.43Ż¼║¼╣╠┬╩3.7%Ż¼ėąÖC┘|║¼┴┐46.5%Ż¼╬█─Ó▒╚ūĶ1.71Ī┴1013 m Īżkg-1Ż¼ZetaļŖ╬╗-31.8 mVŻ¼╬█─Ó¾wĘeųĖöĄ(SVI)×ķ34.6 mL Īżg-1. ▓╔╝»Ą─╬█─Ó▒Ż┤µė┌4Īµ▒∙Žõųą┤²ė├. 1.2 ┼ÓB╗∙
ĪĪĪĪ±RČĪ╩Ž╣╠¾w┼ÓB╗∙Ż║┴ū╦ßČ■ÜõŌø1.0 gŻ¼Ų▀╦«║Ž┴“╦ßµV0.5 gŻ¼Ą░░ūļ╦5.0 gŻ¼ŲŽ╠č╠Ū10.0 g║═Łéų¼15~20 g. īóĖ„│╔Ęų╚▄ĮŌ║¾╝ėš¶s╦«ča│õ¾wĘeų┴1000 mLŻ¼115ĪµĖ▀ē║š¶Ų¹£ńŠ·30 min. ═┴Č╣ŲŽ╠č╠Ūę║¾w┼ÓB╗∙(PDA)Ż║╚Ī╚źŲż═┴Č╣200 gŻ¼Ūą│╔ąĪēKŻ¼╝ėš¶s╦«1 000 mLų¾Ęą30 minŻ¼ė├8īė╝å▓╝▀^×V═┴Č╣ųŁŻ¼×V╚ź═┴Č╣ēKŻ¼╝ėš¶s╦«ča│õ×Vę║¾wĘeų┴1 000 mLŻ¼╝ėŲŽ╠č╠Ū20 gŻ¼115ĪµĖ▀ē║š¶Ų¹£ńŠ·30 min. 1.3 ĮzĀŅšµŠ·Ą─Ęųļx║Y▀x
ĪĪĪĪ▓╔Ą├╬█─Ó┴ó╝┤▀Mąą╬ó╔·╬’Ęųļx. īó▓┐ĘųØŌ┐s╬█─Óų├ė┌28ĪµŻ¼180 r Īżmin-1ōu┤▓ųą┼ÓB12 hŻ¼ų«║¾╠▌Č╚ŽĪßīų┴10-3Īó 10-4║═10-5Ż¼į┘Ęųäe═┐▓╝ĄĮ±RČĪ╩ŽŲĮ░Õ(šµŠ·▀xō±ąį┼ÓB╗∙)╔ŽŻ¼Ę┼ų├ĄĮ28Īµ║Ń£ž┼ÓBŽõųą┼ÓBöĄ╠ņŻ¼Ą├ĄĮČÓųĻšµŠ·Ż¼į┘Ęųäe▀MąąĘųļx╝ā╗»Ż¼▀xō±1ųĻŠ▀ėą▌^║├╬█─Ó├ō╦«ąį─▄Ą─šµŠ·ū„×ķ▒Šįć“×╦∙ė├šµŠ·Š·ųĻ.
ĪĪĪĪĘųūė╔·╬’īWĶbČ©Ż║▓╔ė├OMG╣½╦Š«a╔·Ą─šµŠ·DNAįćä®║ą┐ņ╦┘╠ß╚ĪįōšµŠ·Ą─╗∙ę“ĮMDNAŻ¼▓ó▀MąąPCRöUį÷18S rDNA-ITSą“┴ąŻ¼ę²╬’▓╔ė├šµŠ·ITSą“┴ąöUį÷═©ė├ę²╬’ITS1-Forward (5Īõ-TCCGTAGGT GAACCTGCGG-3Īõ)║═ITS4-Reverse (5Īõ-TCCTCCG CTTATTGATATGC-3Īõ). PCRĘ┤款wŽĄ×ķŻ║Ę┤æ¬ę║┐é¾wĘe×ķ20 ”╠LŻ¼║¼ėą10Ī┴Ex Taq buffer 2.0 ”╠LŻ¼dNTP Mix (2.5 mmol ĪżL-1) 1.6 ”╠LŻ¼5p Primer 1 0.8 ”╠LŻ¼5p Primer 2 0.8 ”╠LŻ¼Template 0.5 ”╠LŻ¼5u Ex Taq 0.2 ”╠LŻ¼│¼╝ā╦«14.1 ”╠L. PCRĘ┤æ¬Śl╝■×ķŻ║95ĪµŅAūāąį5 minŻ¼24éĆ裣h(95Īµūāąį30 sŻ¼55Īµ═╦╗30 sŻ¼72Īµčė╔ņ90 s)Ż¼ūŅĮK72Īµčė╔ņ10 min. PCR«a╬’╬»═ą╔Ž║Ż├└╝¬╔·╬’ßt╦Ä┐Ų╝╝ėąŽ▐╣½╦Š▀MąąļpŽ“£yą“. ų«║¾īó18S rDNA£yą“ĮY╣¹╠ßĮ╗ĄĮNCBIöĄō■Äņ▀MąąBLAST▒╚ī”Ż¼šęĄĮĄõą═Ą─Š·ųĻŽĄ┴ąė├Clustal X2.0▄ø╝■▀Mąą═¼į┤ąį▒╚▌^Ż¼▓ó▓╔ė├Mega 4.0▄ø╝■śŗĮ©ŽĄĮy░lė²śõŻ¼┤_Č©įōŠ·ųĻĄ─ĘųŅÉĄž╬╗.
ĪĪĪĪµ▀ūėæęę║Ą─┼õų├Ż║į┌¤oŠ·ŁhŠ│Ž┬Ż¼╝ėöĄ║┴╔²¤oŠ·╦«ų┴ķLėąšµŠ·Ą─ŲĮ░ÕųąŻ¼ė├▓Ż┴¦ā“░¶öćäė╩╣šµŠ·µ▀ūėø_Ž┤Ž┬üĒŻ¼ė├4īė▓┴ńR╝ł▀^×VŻ¼×Vę║ų├ė┌ļxą─╣▄ųąŻ¼4Īµ▒Ż┤µ┤²ė├Ż¼ė├č¬Ū“ėŗ╦Ń░ÕėŗöĄ. īóµ▀ūėæęę║ŽĪßīų┴107éĆ ĪżmL-1Ż¼╚Ī1 mLŽĪßī║¾µ▀ūėæęę║ĮėĘNų┴═┴Č╣ę║¾w┼ÓB╗∙ųąŻ¼ų├ė┌28ĪµŻ¼120 r Īżmin-1║Ń£žš±╩Äōu┤▓ųą┼ÓB2 d║¾½@Ą├Š·Įzæęę║. ĘųäeįOų├µ▀ūėĮėĘN║═šµŠ·Š·ĮzĮėĘN2ĘN▓╗═¼Ą─ĮėĘNĘĮ╩ĮĮėĘNų┴╬█─ÓųąŻ¼ĮėĘN▒╚└²Š∙×ķ¾wĘe▒╚5%Ż¼ĮėĘN║¾¾wŽĄ┐é¾wĘe×ķ300 mLŻ¼├┐éĆ╠Ä└ĒįOų├3éĆŲĮąąŻ¼ų├ė┌28ĪµŻ¼180 r Īżmin-1║Ń£žš±╩Äōu┤▓ųą┼ÓBŻ¼Ę┤æ¬3 d║¾Ż¼├┐éĆ╠Ä└Ē╚Īśė═┐▓╝ų┴±RČĪ╩Ž┼ÓB╗∙ųąŻ¼Ė∙ō■šµŠ·╔·ķLĀŅør┤_Č©ŲõūŅ▀mĮėĘNĘĮ╩Į. 1.4 ĮzĀŅšµŠ·ĮėĘN┴┐ī”╬█─Ó├ō╦«ąį─▄Ą─ė░Ēæįć“×
ĪĪĪĪīóµ▀ūėæęę║ŽĪßīų┴107éĆ ĪżmL-1Ż¼╚Ī1 mLµ▀ūėæęę║ĮėĘNų┴═┴Č╣ę║¾w┼ÓB╗∙ųąŻ¼ų├ė┌28ĪµŻ¼120 r Īżmin-1║Ń£žš±╩Äōu┤▓ųą┼ÓB2 d║¾½@Ą├Š·Įzæęę║. Ž“╩ŻėÓ╬█─ÓųąĮė╚ļ┤╦Š·Įzæęę║Ż¼ę└¾wĘe▒╚įOėŗ6éĆ▓╗═¼Ą─ĮėĘN┴┐╠Ä└ĒŻ¼Ęųäe×ķCK(▓╗ĮėŠ·)Īó 1%Īó 3%Īó 5%Īó 10%║═20%Ż¼┐é¾wĘe×ķ300 mLŻ¼├┐éĆ╠Ä└ĒįOų├3éĆŲĮąąŻ¼ų├ė┌28ĪµŻ¼180 r Īżmin-1║Ń£žš±╩Äōu┤▓ųą┼ÓBŻ¼├┐╠ņČ©Ģr╚Īśė£yČ©╬█─Ó▒╚ūĶųĄŻ¼ęį┤_Č©ūŅ▀mšµŠ·ĮėĘN┴┐. 1.5 ╬█─Ó║¼╣╠┬╩ī”╬█─Ó├ō╦«ąį─▄Ą─ė░Ēæįć“×
ĪĪĪĪīóµ▀ūėæęę║ŽĪßīų┴107éĆ ĪżmL-1Ż¼╚Ī1 mLŽĪßī║¾µ▀ūėæęę║ĮėĘNų┴═┴Č╣ę║¾w┼ÓB╗∙ųąŻ¼ų├ė┌28ĪµŻ¼120 r Īżmin-1║Ń£žš±╩Äōu┤▓ųą┼ÓB2 d║¾½@Ą├Š·Įzæęę║. īóįŁ╩╝╬█─ÓĘųäeŽĪßīų┴║¼╣╠┬╩×ķ0.5%Īó 2%║═3.7%(╬┤ŽĪßī)3éĆØŌČ╚╠▌Č╚Ż¼╚╗║¾ĘųäeŽ“ŲõųąĮė╚ļ10%Š·Įzæęę║Ż¼▓óĘųäeįOų├▓╗╝ėŠ·Įzæęę║Ą─┐š░ū╠Ä└ĒŻ¼┐é¾wĘe×ķ300 mLŻ¼├┐éĆ╠Ä└ĒįOų├3éĆŲĮąąŻ¼ų├ė┌28ĪµŻ¼180 r Īżmin-1║Ń£žš±╩Äōu┤▓ųą┼ÓBŻ¼├┐╠ņČ©Ģr╚Īśė£yČ©╬█─Ó▒╚ūĶŻ¼ęį┤_Č©šµŠ·╠Ä└ĒĄ─ūŅ▀m╬█─Ó║¼╣╠┬╩.
ĪĪĪĪį┌┤_Č©ūŅ▀mĮėĘNĘĮ╩ĮĪó ūŅ▀mĮėĘNØŌČ╚║═ūŅ▀m╬█─Ó║¼╣╠┬╩Ą─╗∙ĄA╔ŽŻ¼▀Mę╗▓ĮĻU├„ĮzĀŅšµŠ·┤┘▀M╬█─Ó├ō╦«ąį─▄Ė─╔ŲĄ─ÖCųŲŻ¼įć“×įOų├ĮėĘNūŅ▀m┴┐šµŠ·║═▓╗ĮėŠ·ā╔éĆ╠Ä└ĒŻ¼├┐éĆ╠Ä└Ē3éĆŲĮąąŻ¼ų├ė┌28ĪµŻ¼180 r Īżmin-1║Ń£žš±╩Äōu┤▓ųą┼ÓBŻ¼├┐╠ņČ©Ģr╚Īśė£yČ©╬█─ÓpHĪó ╬█─Ó▒╚ūĶĪó CSTĪó ZetaļŖ╬╗Īó ╬█─Ó¾wĘeųĖöĄĪó ╬█─Ó╔ŽŪÕę║COD║═╬█─ÓEPS║¼┴┐. 1.6 £yČ©ĘĮĘ©
ĪĪĪĪ▓╔ė├pHS-3CŠ½├▄pHėŗ(╔Ž║Ż└ū┤┼ÅS)£yČ©╬█─ÓĄ─pHųĄ; ZetaļŖ╬╗ųĄ═©▀^Colloidal Dynamic ZetaļŖ╬╗£yČ©āx£yČ©; ╬█─ÓĄ─▒╚ūĶ(SRF)▓╔ė├▓╝╩Ž×VČĘ-šµ┐š│ķ×VĘ©£yČ©[17,18]; ╬█─Ó├½╝Ü╬³╦«Ģrķg(CST)▓╔ė├CST£yČ©āx(TYPE 304MŻ¼ėóć°Triton╣½╦Š)£yČ©; ╬█─Ó¾wĘeųĖöĄ(SVI)Ż║╚Ī100 mL╬█─Óōuä“║¾Ż¼Ą╣╚ļ100 mL┴┐═▓ųąŻ¼ņoų╣│┴ĮĄ30 min║¾Ż¼ėøõø╬█─Ó¾wĘeV(mL)Ż¼║µĖ╔£yČ©╬█─Ó┘|┴┐m(g)Ż¼ätSVI=V/m(ęįTSSėŗŻ¼mL Īżg-1); COD▓╔ė├Orion COD ThermoreactorĘų╬÷āx£yČ©.
ĪĪĪĪEPSĄ─╠ß╚Ī┼c£yČ©[19]Ż║īó╬█─Óį┌15 000 r Īżmin-1Ż¼4ĪµŽ┬ļxą─20 minŻ¼╔ŽŪÕę║▀^0.45 ”╠m×V─żŻ¼╦∙Ą├×Vę║╝┤×ķ╬█─Ó┐éEPSŻ¼EPS║¼┴┐═©▀^TOCĘų╬÷āx(SHIMADZU TOC-5000A)£yČ©. 2 ĮY╣¹┼cėæšō 2.1 ĮzĀŅšµŠ·Ą─Ęųļx╝░ŲõūŅ▀mĮėĘNĘĮ╩ĮĄ─┤_Č©
ĪĪĪĪ▓╔ė├±RČĪ╩Ž┼ÓB╗∙Å─╬█─Óųą║Y▀xŠ·ĘNŻ¼īó½@Ą├Ą─▓╗═¼šµŠ·▀MąąĘųļx╝ā╗»║¾Ż¼▀Mąąę║¾w┼ÓBŻ¼╚╗║¾▓╔ė├ę║¾w┼ÓBę║Ęųäeū÷šµŠ·╬█─Ó├ō╦«įć“×. ═©▀^▒╚▌^╬█─Óį┌▓╗═¼šµŠ·╠Ä└ĒŽ┬Ą─Ą─├ō╦«ąį─▄Ż¼ūŅ║¾▀xČ©1ųĻėąūŅ╝č╬█─Ó├ō╦«ą¦╣¹Ą─šµŠ·Š·ųĻŻ¼═©▀^£yą“║══¼į┤ąį▒╚▌^ī”Ųõ▀MąąĶbČ©Ż¼┤_Č©įōšµŠ·×ķ├½├╣ī┘. įōĮzĀŅšµŠ·Š·ųĻŠÄ╠¢×ķMucor circinelloides ZG-3(Ž┬╬─ųą║åĘQ×ķM. circinelloides ZG-3)Ż¼▀M╗»śõ╚ńłD 1╦∙╩Š. įōŠ·į┌±RČĪ╩Ž┼ÓB╗∙╔ŽŠ·Įz×ķĄŁ³S╔½Ż¼Š·Įz▌^ķLŻ¼į┌═┴Č╣ę║¾w┼ÓB╗∙ųą┼ÓB2 d║¾Ż¼Š·ĮzĘų╔óŠ∙ä“Ż¼▓╗ŽÓ╗ź└p└@│╔Š·ĮzŪ“.

ĪĪĪĪłD 1 M. circinelloides ZG-3╝░ŲõŽÓĻPŠ·ųĻĄ─ITSŽĄĮy░lė²śõ
ĪĪĪĪĘųäeęįšµŠ·µ▀ūė║═šµŠ·Š·Įzą╬╩Įīó┤╦Š·ĮėĘNų┴╩ŻėÓ╬█─ÓųąŻ¼┼ÓB3 d║¾Ż¼īó╬█─ÓśėŲĘ═┐▓╝ė┌PDAŲĮ░Õ╔ŽŻ¼┼ÓB║¾░l¼FŻ¼ęįŠ·ĮzĮėĘNĄ─šµŠ·╔·ķLĀŅør┴╝║├Ż¼Č°ęįµ▀ūėæęę║ĮėĘNĄ─šµŠ·ät╔·ķLŠÅ┬²(łD 2). ę“┤╦Ż¼Š·ĮzĮėĘN╩ŪīóM. circinelloides ZG-3ĮėĘNų┴╬█─ÓųąĄ─ūŅ▀mĮėĘNĘĮ╩Į.
ĪĪĪĪłD 2 ęįšµŠ·µ▀ūė║═šµŠ·Š·Įzą╬╩ĮĮėĘNM. circinelloides ZG-3ų┴╬█─Ó▓ó┼ÓB3 d║¾Ą─╔·ķLŪķør
ĪĪĪĪ2.2 ĮzĀŅšµŠ·ĮėĘN┴┐ī”╬█─Ó├ō╦«ąį─▄Ą─ė░Ēæ
ĪĪĪĪĮzĀŅšµŠ·ĮėĘN┴┐ī”╬█─Ó├ō╦«ąį─▄Ą─╠ßĖ▀ėąųžę¬ė░ĒæŻ¼ų„ę¬▒Ē¼Fį┌▀^Ą═Ą─ĮzĀŅšµŠ·ĮėĘN┴┐ī”╬█─Ó├ō╦«ąį─▄Ą─╠ßĖ▀ū„ė├▓╗’@ų°Ż¼Č°▀^Ė▀Ą─ĮzĀŅšµŠ·ĮėĘN┴┐ätėą┐╔─▄╩╣╬█─ÓĄ─├ō╦«ąį─▄į┌╠Ä└Ē║¾│÷¼FÉ║╗»[14]. łD 3×ķ▓╔ė├▓╗═¼ĮėĘN┴┐Ą─ĮzĀŅšµŠ·M. circinelloides ZG-3╠Ä└Ē╩ŻėÓ╬█─Ó▀^│╠ųą▒╚ūĶ║═▒╚ūĶĮĄĄ═┬╩Ą─ūā╗». ╚ńłD 3(a)╦∙╩ŠŻ¼į┌▓╗ĮėĘNĮzĀŅšµŠ·Č°ų╗ī”╬█─Ó▀Mąą║├č§┼ÓBĄ─┐š░ūī”ššųąŻ¼╬█─ÓĄ─▒╚ūĶųĄį┌┼ÓBĄ─▀^│╠ųąŽ╚ĮĄĄ═║¾╔²Ė▀Ż¼┤╦ĮY╣¹┼cŲõ╦¹īWš▀Ą─蹊┐ĮY╣¹ę╗ų┬Ż¼ŲõįŁę“┐╔─▄╩Ū║├č§┼ÓBŚl╝■Ž┬╬█─Óųą╬ó╔·╬’░¹═ŌŠ█║Ž╬’░l╔·ĮĄĮŌŻ¼Å─Č°į┌ę╗Č©│╠Č╚╔ŽĖ─╔Ų┴╦╬█─ÓĄ─├ō╦«ąį─▄[20]. ĮėĘN1%Īó 3%Īó 5%║═20%Ą─ĮzĀŅšµŠ·Ą─╠Ä└Ēųą╬█─Ó▒╚ūĶųĄĄ─ūā╗»┌ģä▌┼c┐š░ūī”ššę╗ų┬Ż¼į┌┼ÓBĄ─Ą┌3 d▀_ĄĮūŅĄ═╬█─Ó▒╚ūĶųĄŻ¼ų«║¾ųØu╔Ž╔². Č°ĮėĘN10%ĮzĀŅšµŠ·Ą─╠Ä└Ēųą╬█─Ó▒╚ūĶųĄätį┌6 dĄ─┼ÓBŲ┌ā╚ę╗ų▒│╩Ž┬ĮĄ┌ģä▌Ż¼Ą┌6 dĢr╬█─ÓĄ─▒╚ūĶųĄĮĄ×ķ5.23Ī┴1012 m Īżkg-1.
ĪĪĪĪ╬█─ÓĄ─▒╚ūĶĮĄĄ═┬╩┐╔ęįÅ─┴Ēę╗ĘĮ├µėąą¦ĄžĘ┤ė│╬█─Ó├ō╦«ąį─▄Ą─Ė─╔Ųą¦╣¹[21]. łD 3(b)×ķ▓╗═¼Š·Įz¾wĮėĘNØŌČ╚Ž┬▒╚ūĶĮĄĄ═┬╩Ą─ūā╗». Å─ųą┐╔ų¬Ż¼ĮėĘN┴┐×ķ1%Īó 3%║═5%Ą─╠Ä└ĒĄ─▒╚ūĶĮĄĄ═┬╩┬įĖ▀ė┌▓╗ĮėĮzĀŅšµŠ·Ą─┐š░ūī”ššŻ¼Ą½├„’@Ą═ė┌ĮėĘN┴┐×ķ10%║═20%Ą─╠Ä└Ē. ▒M╣▄ĮėĘN┴┐×ķ20%Ą─╠Ä└ĒųąŻ¼▒╚ūĶĮĄĄ═┬╩į┌Ą┌5 d┐╔▀_ĄĮūŅ┤¾Ą─78.4%Ż¼Ą½┼ÓBūŅ║¾1 dĮĄų┴57.7%. Č°ĮėĘN┴┐×ķ10%Ą─╠Ä└Ēųą▒╚ūĶĮĄĄ═┬╩│ų└m╔Ž╔²Ż¼▓óį┌Ą┌6 d▀_ĄĮūŅ┤¾ųĄ75.1%. ę“┤╦Ż¼ī”ė┌▓╔ė├ĮzĀŅšµŠ·M. circinelloides ZG-3╠Ä└Ē╩ŻėÓ╬█─ÓČ°čįŻ¼▓╔ė├10%Ą─ĮėĘN┴┐┐╔ęįį┌┼ÓB▀^│╠ųąėąą¦Ė─╔Ų╬█─ÓĄ─├ō╦«ąį─▄Ż¼ĮĄĄ═╬█─ÓĄ─▒╚ūĶųĄ.

ĪĪĪĪłD 3 ▓╗═¼Š·Įz¾wØŌČ╚Ą─M. circinelloides ZG-3╠Ä└Ē╬█─Ó▀^│╠ųą╬█─Ó▒╚ūĶ╝░▒╚ūĶĮĄĄ═┬╩Ą─ūā╗»
ĪĪĪĪ2.3 ▓╗═¼╬█─Ó║¼╣╠┬╩ī”╬█─Ó├ō╦«ąį─▄Ą─ė░Ēæ
ĪĪĪĪ▓╔ė├ĮzĀŅšµŠ·M. circinelloides ZG-3╠Ä└Ē▓╗═¼║¼╣╠┬╩(0.5%Īó 2%Īó 3.7%)╬█─Ó▀^│╠ųąŻ¼╬█─Ó▒╚ūĶųĄĄ─ūā╗»╚ńłD 4╦∙╩Š. Å─ųą┐╔ų¬Ż¼«ö╬█─Ó║¼╣╠┬╩×ķ0.5%ĢrŻ¼ĮzĀŅšµŠ·╠Ä└Ē▓╗─▄ėąą¦┤┘▀M╬█─Ó▒╚ūĶĄ─ĮĄĄ═Ż¼▀_▓╗ĄĮĖ─╔Ų╬█─Ó├ō╦«ąį─▄Ą──┐Ą─. ŲõįŁę“┐╔─▄┼cĮzĀŅšµŠ·ĮėĘNį÷┤¾╬█─ÓĄ─│§╩╝▒╚ūĶųĄėąĻPŻ¼ę“×ķį┌0 dĢrŽ“║¼╣╠┬╩×ķ0.5%Ą─╬█─ÓųąĮėĘNĮzĀŅšµŠ·║¾Ż¼Ųõ▒╚ūĶųĄ▀_ĄĮ1.313Ī┴1013 m Īżkg-1Ż¼╩Ū╬┤ĮėĘNĄ─┐š░ū╬█─ÓĄ─5▒Č. į┌Ųõ║¾Ą─┼ÓB▀^│╠ųąŻ¼ī”ė┌║¼╣╠┬╩×ķ0.5%║═2%Ą─ā╔éĆ╠Ä└ĒŻ¼ļm╚╗ĮėĘNĮzĀŅšµŠ·Ą─╠Ä└Ēųą╬█─ÓĄ─▒╚ūĶųĄ├„’@ĮĄĄ═Ż¼Ą½╚į╬┤├„’@Ą═ė┌▓╗ĮėĘNĮzĀŅšµŠ·Ą─ī”šš╬█─ÓĄ─▒╚ūĶ. ę“┤╦Ż¼▓╔ė├ĮzĀŅšµŠ·M. circinelloides ZG-3╠Ä└ĒĄ═║¼╣╠┬╩Ą─╬█─ÓĢrŻ¼ī”╬█─Ó├ō╦«ąį─▄Ą─Ė─╔Ųą¦╣¹▓╗├„’@Ż¼╔§ų┴ėą┐╔─▄╩╣╬█─Ó├ō╦«ąį─▄É║╗». Č°▓╔ė├M. circinelloides ZG-3ī”3.7%Ą─įŁ╩╝╩ŻėÓ╬█─Ó▀Mąą╠Ä└ĒĢrŻ¼╬█─ÓĄ─├ō╦«ąį─▄ät┐╔ęįĄ├ĄĮ┤¾Ę∙Č╚Ą─Ė─╔Ų. ╚ńłD 4╦∙╩ŠŻ¼į┌0 dĢrŽ“3.7%Ą─╬█─ÓųąĮėĘNĮzĀŅšµŠ·║¾Ż¼╬█─ÓĄ─▒╚ūĶųĄ×ķ2.87Ī┴1012 m Īżkg-1Ż¼├„’@Ą═ė┌╬┤ĮėĘNĄ─┐š░ūī”šš. Ųõ║¾Ż¼ļSų°Ę┤æ¬Ą─▀MąąŻ¼╬█─ÓĄ─▒╚ūĶųĄ▀Mę╗▓ĮĮĄĄ═Ż¼į┌╠Ä└Ē3 dĢrĮĄ×ķūŅĄ═Ż¼āH×ķ8.4Ī┴1011 m Īżkg-1Ż¼┼cįŁ╩╝╩ŻėÓ╬█─ÓĄ─▒╚ūĶųĄŽÓ▒╚ĮĄĄ═┴╦74%Ż¼’@╩Š│÷ĮzĀŅšµŠ·M. circinelloides ZG-3╠Ä└ĒĖ▀║¼╣╠┬╩╬█─ÓĢr┴╝║├Ą─ą¦╣¹. ę“┤╦Ż¼▓╔ė├ĮzĀŅšµŠ·M. circinelloides ZG-3╠Ä└Ē╬█─ÓÅ─Č°Ė─╔Ų╬█─Ó├ō╦«ąį─▄ĢrŻ¼┐╔ų▒Įėī”║¼╣╠┬╩×ķ4%ū¾ėęĄ─įŁ╩╝╬█─Ó▀Mąą╠Ä└ĒŻ¼Č°╠Ä└Ē║¼╣╠┬╩×ķ0.5%~2%Ą─╬█─ÓĢrŻ¼ätąĶŽ╚īó╬█─ÓØŌ┐sų┴4%ū¾ėęŻ¼╚╗║¾į┘▀MąąĮzĀŅšµŠ·╠Ä└Ē.

ĪĪĪĪłD 4 ĮzĀŅšµŠ·M. circinelloides ZG-3╠Ä└Ē▓╗═¼║¼╣╠┬╩╬█─Ó▀^│╠ųą╬█─Ó▒╚ūĶĄ─ūā╗»
ĪĪĪĪ2.4 ĮzĀŅšµŠ·╠Ä└ĒĖ─╔Ų╬█─Ó├ō╦«ąį─▄Ą─ÖCųŲ│§╠Į
ĪĪĪĪ×ķ┴╦▀Mę╗▓ĮĻU├„ĮzĀŅšµŠ·┤┘▀M╬█─Ó├ō╦«ąį─▄Ė─╔ŲĄ─ÖCųŲŻ¼čąŠ┐┴╦ĮėĘN10%ĮzĀŅšµŠ·M. circinelloides ZG-3╠Ä└Ē║¼╣╠┬╩×ķ3.7%Ą─įŁ╩╝╩ŻėÓ╬█─Ó▀^│╠ųą╬█─ÓpHųĄĪó ╬█─ÓZetaļŖ╬╗Īó ╬█─Óųą╬ó╔·╬’░¹═ŌŠ█║Ž╬’(EPS)┐é┴┐Ą─ūā╗»Ż¼ĮY╣¹╚ńłD 5╦∙╩Š. ė╔łD 5(a)┐╔ų¬Ż¼10%ĮzĀŅšµŠ·╠Ä└ĒįŁ╩╝╩ŻėÓ╬█─ÓĄ─▀^│╠ųąŻ¼╬█─ÓĄ─pHųĄųØuĮĄĄ═Ż¼ŲõĮĄĄ═Ę∙Č╚┤¾ė┌╬┤ĮėĘNĮzĀŅšµŠ·Ą─ī”šš╠Ä└ĒŻ¼╠Ä└Ē6 d║¾Ż¼╬█─ÓpHųĄÅ─│§╩╝Ą─7.09ĮĄĄ═ų┴4.97.ŲõįŁę“┐╔─▄╩ŪM. circinelloides ZG-3╔·ķL▀^│╠ųą┐╔ęį┤·ųx╬█─ÓųąĄ─ėąÖC╬’Å─Č°Ęų├┌ę╗ą®╦ßąį┤·ųx╬’[22]Ż¼┴Ēę╗ĘĮ├µėąčąŠ┐░l¼F╬█─ÓpHųĄĄ─ĮĄĄ═┐╔ęį┤┘▀M▓┐Ęų╬█─ÓEPSĄ─ĘųĮŌŻ¼Å─Č°ėąų·ė┌╬█─Ó├ō╦«ąį─▄Ą─Ė─╔Ų[20]. łD 5(b)×ķ╠Ä└Ē▀^│╠ųą╬█─ÓZetaļŖ╬╗Ą─ūā╗»Ż¼Å─ųą┐╔ų¬Ż¼ė╔ė┌Įė╚ļ┴╦ĮzĀŅšµŠ·M. circinelloides ZG-3Ż¼ī¦ų┬0 dĢr╬█─ÓZetaļŖ╬╗ųĄ╔²Ė▀Ż¼Ą½ļSų°Ę┤æ¬▀MąąŻ¼╠Ä└Ē┼cī”ššų«ķgZetaļŖ╬╗ųĄūā╗»¤o▓Ņ«ÉŻ¼ā╔š▀Š∙╩ŪųØu╔Ž╔². Ė∙ō■DLVO└ĒšōŻ¼ZetaļŖ╬╗╩ŪĘ┤ė│─z¾w║═æęĖĪ╬’ĘĆČ©ąįĄ─ųžę¬ųĖś╦Ż¼ZetaļŖ╬╗žōųĄįĮ┤¾Ż¼šf├„╬█─Óą§¾wķgņoļŖ┼┼│ŌįĮ┤¾Ż¼ūŅĮKī¦ų┬╬█─Óą§¾wŅw┴ŻūāąĪ▓╗ęūą§─²Ż¼╩╣Ą├│┴ĮĄ╝░├ō╦«ąį─▄ūā▓Ņ[23]. ę“┤╦║├č§┼ÓB▀^│╠ųąŻ¼╬█─ÓZetaļŖ╬╗ųĄĄ─╔²Ė▀ī”ė┌╬█─Ó├ō╦«ąį─▄Ą─Ė─╔Ųæ¬įōę▓ėąę╗Č©│╠Č╚Ą─žĢ½IŻ¼Ą½▓óĘŪ╩Ūī¦ų┬ĮėĘNĮzĀŅšµŠ·╠Ä└Ēā×ė┌╬┤ĮėĘNĄ─┐š░ūī”šš╠Ä└ĒĄ─ų„ę¬įŁę“Ż¼ę“×ķį┌ā╔éĆ╠Ä└Ē▀^│╠ųą╬█─ÓZetaļŖ╬╗Ą─▓Ņ«É▓ó▓╗├„’@. ─┐Ū░Ż¼ęčėą┤¾┴┐蹊┐▒Ē├„Ż¼╬█─Óųą┤µį┌Ą─┤¾┴┐╬█─ÓEPS╩ŪŲõ├ō╦«└¦ļyĄ─ų„ę¬įŁę“[19, 20, 21, 22, 23, 24, 25, 26]. ▒ŠčąŠ┐░l¼FŻ¼į┌ĮzĀŅšµŠ·M. circinelloides ZG-3╠Ä└Ē╩ŻėÓ╬█─ÓĄ─▀^│╠ųąŻ¼ĮėĘNĮzĀŅšµŠ·Ą─╠Ä└Ē║═╬┤ĮėĘNĄ─┐š░ūī”ššųą╬█─ÓEPS┐é┴┐į┌┼ÓB▀^│╠ųąČ╝╩Ūų▓ĮĮĄĄ═Ż¼┼ÓB2 d║¾ĮėĘNĮzĀŅšµŠ·╠Ä└ĒųąĄ─EPS┐é┴┐ęčĮøĄ═ė┌┐š░ūī”ššųąEPSĄ─┐é┴┐. ĮY║ŽŲõ╦¹īWš▀Ą─蹊┐Ż¼┐╔ęį═Ų£yŻ¼ĮzĀŅšµŠ·M. circinelloides ZG-3╠Ä└Ē╩ŻėÓ╬█─Ó▀^│╠ųąŻ¼╬█─ÓEPSĄ─ĮĄĮŌę▓╩Ū╬█─Ó├ō╦«ąį─▄Ė─╔ŲĄ─įŁę“ų«ę╗[20]. ę“┤╦Ż¼ĮzĀŅšµŠ·M. circinelloides ZG-3╠Ä└ĒĖ─╔Ų╬█─Ó├ō╦«ąį─▄Ą─ÖCųŲų„ę¬░³└©╬█─ÓpHųĄĄ─ĮĄĄ═║═╬█─Óųą┐éEPSĄ─ĮĄĮŌ.

ĪĪĪĪłD 5 ĮzĀŅšµŠ·M. circinelloides ZG-3╠Ä└Ē╬█─Ó▀^│╠ųą╬█─ÓpHųĄĪó ╬█─ÓZetaļŖ╬╗╝░╬█─ÓEPS║¼┴┐Ą─ūā╗»
ĪĪĪĪ╬█─Ó╔ŽŪÕę║CODųĄ║═╬█─Ó¾wĘeųĖöĄ(SVI)┐╔ęįĘųäe║Ō┴┐╠Ä└Ē║¾╬█─Ó╔ŽŪÕę║╦«┘|Ūķør║═╬█─Ó│┴ĮĄąį─▄. ╚ńłD 6(a)ĮY╣¹’@╩ŠŻ¼ė╔ė┌╝ė╚ļšµŠ·┼ÓBę║Ż¼ī¦ų┬šµŠ·╠Ä└ĒŪ░Ų┌╬█─Ó╔ŽŪÕę║ųąCOD┴┐▀hĖ▀ė┌┐š░ū╠Ä└ĒŻ¼Ą½ļSų°Ę┤æ¬Ą─▀MąąŻ¼ĮzĀŅšµŠ·┐ņ╦┘└¹ė├╬█─ÓųąĄ─ėąÖC╬’Ż¼┼ÓB1 d║¾ĮzĀŅšµŠ·╠Ä└ĒųąĄ─╬█─Ó╔ŽŪÕę║CODųĄ┤¾Ę∙ĮĄĄ═Ż¼▓óį┌╠Ä└Ē║¾Ų┌ķ_╩╝Ą═ė┌┐š░ū╠Ä└ĒŻ¼╠Ä└Ē5 d║¾Ż¼Ųõ╔ŽŪÕę║CODųĄāH×ķ310 mg ĪżL-1ū¾ėę. įōĮY╣¹┼c▒ŖČÓ蹊┐š▀Ą─ĮY╣¹ę╗ų┬[14, 21, 28]Ż¼’@╩ŠĮzĀŅšµŠ·╠Ä└Ē┐╔ęį▀_ĄĮ╚ź│²╬█─Ó╚▄ę║ųąCODĄ──┐Ą─. ┴Ēę╗ĘĮ├µŻ¼╚ńłD 6(b)╦∙╩ŠŻ¼ĮėĘNĮzĀŅšµŠ·Ą─╠Ä└Ē╬█─ÓĄ─SVIųĄį┌┼ÓBĄ─Ą┌1 dė╔34.6 mL Īżg-1╔Ž╔²ų┴37.9 mL Īżg-1Ż¼ų«║¾ät▒Ż│ų▓╗ūāŻ¼Č°ī”ššĮMĄ─SVIųĄę╗ų▒ĘĆČ©į┌35 mL Īżg-1ū¾ėęŻ¼šf├„ĮzĀŅšµŠ·╠Ä└Ē╬█─Ó▀^│╠ųąŻ¼╬█─Ó╚įŠ▀ėą┴╝║├Ą─│┴ĮĄąį─▄Ż¼ĮzĀŅšµŠ·╠Ä└Ē▓ó╬┤ī¦ų┬╬█─ÓÉ║╗»Ż¼ę²Ų╬█─Ó┼“├øĄ─å¢Ņ}[29].
Š▀¾wģóęŖ╬█╦«īÜ╔╠│Ū┘Y┴Ž╗“http://www.bnynw.comĖ³ČÓŽÓĻP╝╝ąg╬─ÖnĪŻ
ĪĪĪĪłD 6 ĮzĀŅšµŠ·M. circinelloides ZG-3╠Ä└Ē╬█─Ó▀^│╠ųą│÷╦«COD║═╬█─ÓSVIĄ─ūā╗»
ĪĪĪĪ3 ĮYšō
ĪĪĪĪÅ─╩ŻėÓ╬█─Óųą│╔╣”ĘųļxĄĮ1ųĻ┐╔ęį╠ßĖ▀╬█─Ó├ō╦«ąį─▄Ą─ĮzĀŅšµŠ·M. circinelloides ZG-3Ż¼įōĮzĀŅšµŠ·╠Ä└Ē╩ŻėÓ╬█─Ó▀^│╠ųą╬█─ÓĄ─├ō╦«ąį─▄Ė─╔Ųą¦╣¹ų„ę¬╩▄ĄĮĮėĘNĘĮ╩ĮĪó ĮėĘNØŌČ╚║═╬█─Ó║¼╣╠┬╩Ą─ė░ĒæŻ¼ŲõūŅ▀mĮėĘNĘĮ╩Į×ķŠ·Įz¾wĮėĘNŻ¼¾wĘeĮėĘNØŌČ╚×ķ10%Ż¼ūŅ▀m╬█─Ó║¼╣╠┬╩╝s×ķ4%. M. circinelloides ZG-3╠Ä└Ē╩ŻėÓ╬█─Ó▀^│╠ųąŻ¼╬█─Ó├ō╦«ąį─▄Ą─Ė─╔Ųų„ę¬┼c╬█─ÓEPSĄ─ĮĄĮŌ║═╬█─ÓpHĄ─ĮĄĄ═ėąĻP.(üĒį┤╝░ū„š▀Ż║─ŽŠ®▐rśI┤¾īW┘Yį┤┼cŁhŠ│┐ŲīWīWį║ ų▄ėĻ¼BĪóĖČ║└ę▌ĪóĘČŽ╚õhĪó═§š±ėŅĪóÓŹ╣┌ėŅ)


